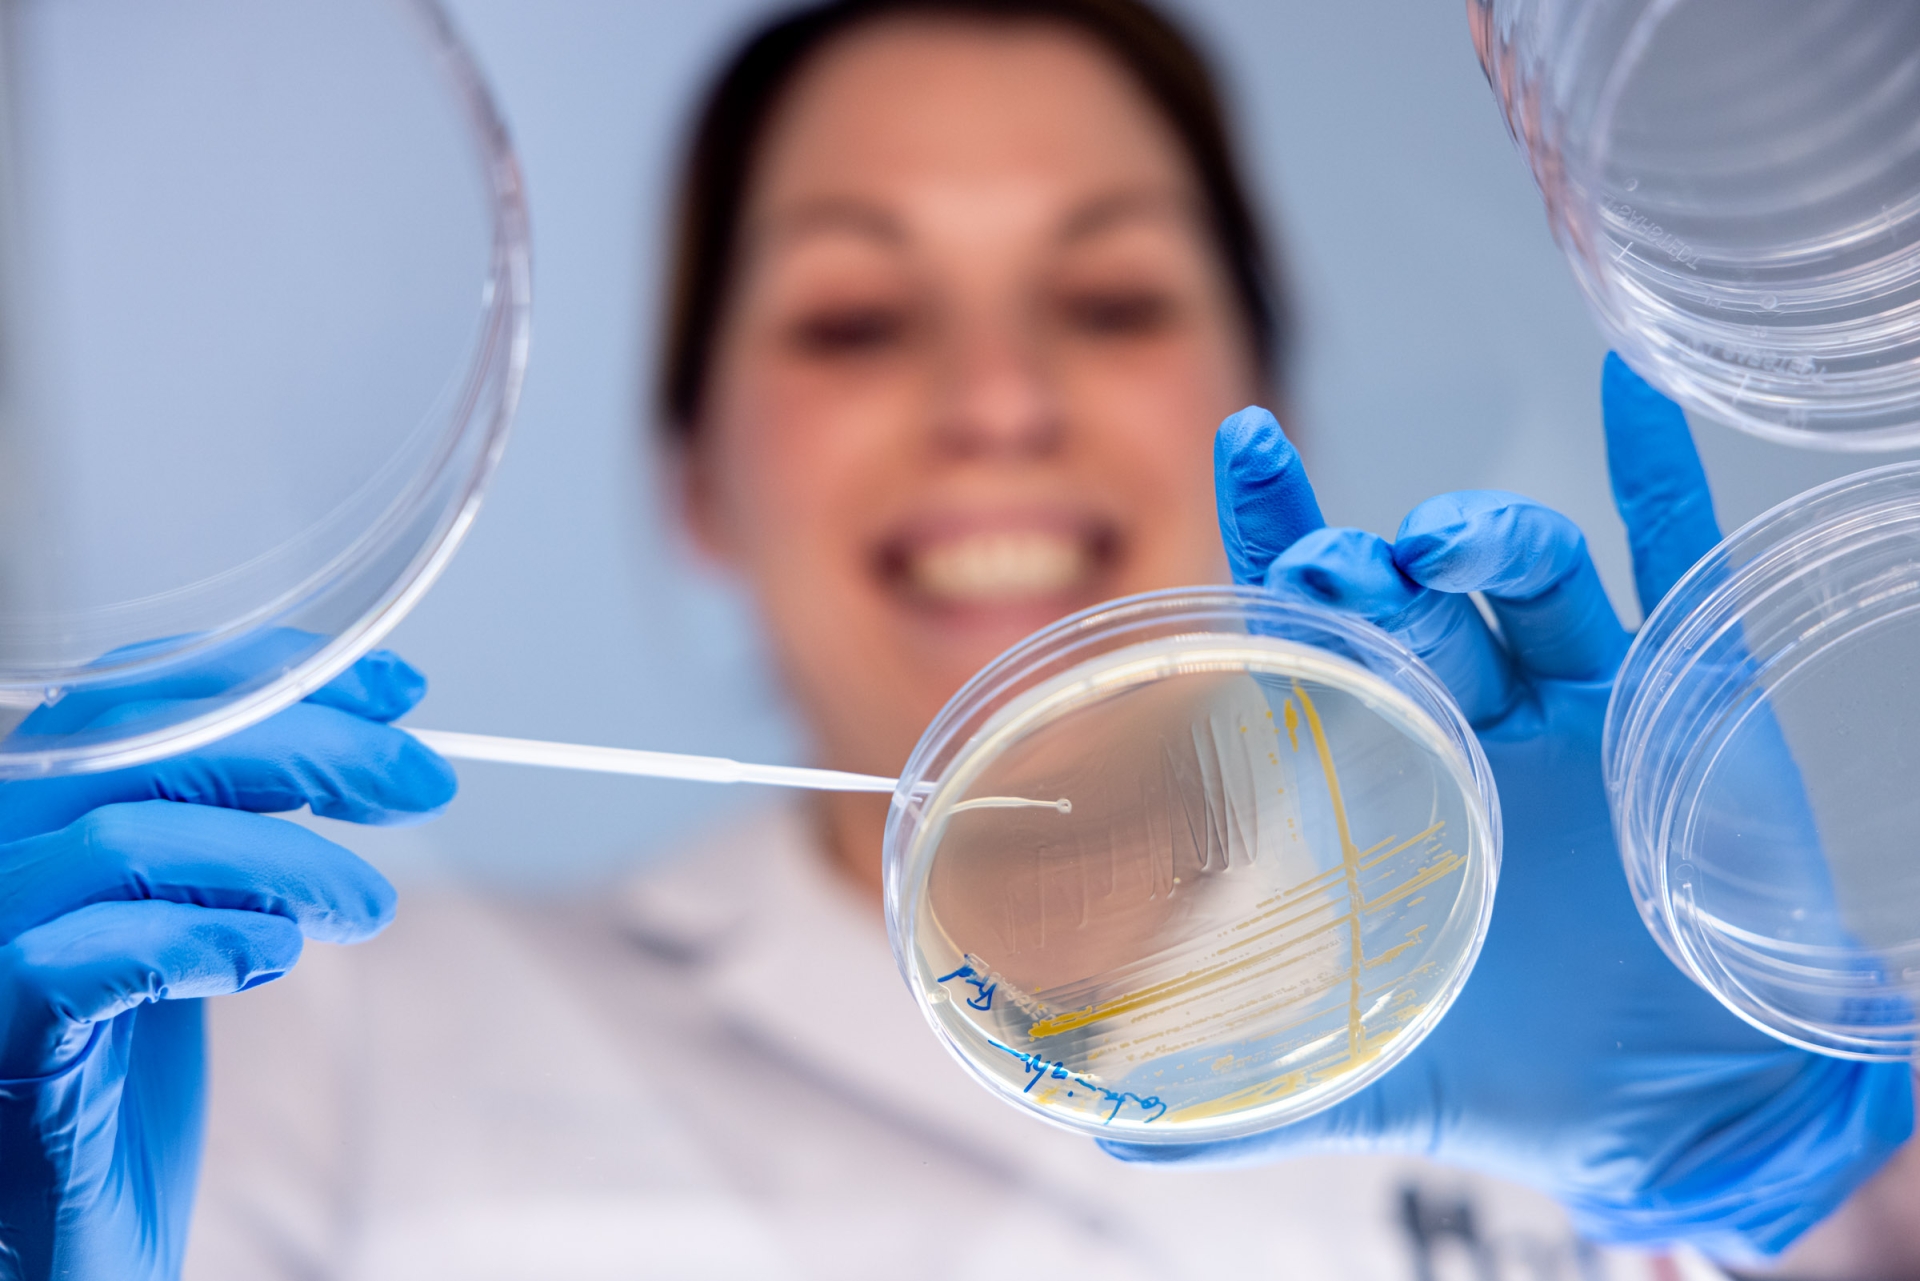

På BioInvent kombinerar vi djup immunologisk förståelse med ”function first, target-agnostic” screening (målstruktur identifieras efter att funktionell aktivitet visats) för att identifiera de kliniskt mest relevanta målen och antikropparna för immunterapi mot cancer. Patientens celler, tillsammans med vår teknikplattform F.I.R.S.T™ och det humana antikroppsbiblioteket n-CoDeR är hörnstenar i denna process. Genom att applicera spjutspetsforskning på immunsystemet och de mekanismer som kan bryta resistens i tumörens mikromiljö, identiferar och utvecklar vi nästa generationens immunterapibehandling av cancer.
TEKNOLOGIPLATTFORMAR
Med det unika utvecklingsverktyget F.I.R.S.T™, där patientmaterial utgör grunden genom hela utvecklingsprocessen, identifieras både kliniskt relevanta målstrukturer och därtill matchande antikroppar. Det egenutvecklade antikroppsbiblioteket n-CoDeR® innehåller antikroppar som binder specifikt och starkt till sina målstrukturer.
TUMÖR-ASSOCIERADE MYELOIDA CELLER (TAM)
Myeloida celler är centrala i vårt medfödda, icke-specifika, immunförsvar, men kan också ”kapas” av tumörer för att stötta tillväxt och spridning av cancer. Antikroppsmedierad ”omprogrammering” av immunsuppressiva TAMs som kan utgöra en signifikant del av den totala tumörmassan, är ett attraktiv koncept. BioInvent och dess samarbetspartners befinner sig i frontlinjen av detta område.
T-CELLER (TREGS OCH EFFEKTOR-T-CELLER)
Effektor T-celler är bland de mest kraftfulla cellerna i immunsystemet vad gäller avdödning av tumörceller och i att förebygga och bota cancer. Dessvärre bromsas dess aktivitet i cancer ofta av tumör-inducerade immunsuppressiva celler såsom regulatoriska T-celler (Tregs). Många vetenskapliga publikationer visar på en tydlig koppling mellan kvoten effektor-T-celler/Tregs och överlevnad. BioInvent utvecklar antikroppar som slår mot Tregs och tumör-associerade myeloida celler och som hjälper effektor-T-celler att föröka sig och aktiveras att specifikt avdöda cancerceller. Aktivering av effektor-T-celler genom immuncheckpoint-blockad är ett kliniskt erkänt koncept.

Vår teknologi
BioInvent har en unik teknologiplattform där de kliniskt mest relevanta målstrukturerna i en sjukdomsmodell och därtill matchande antikroppar identifieras samtidigt.